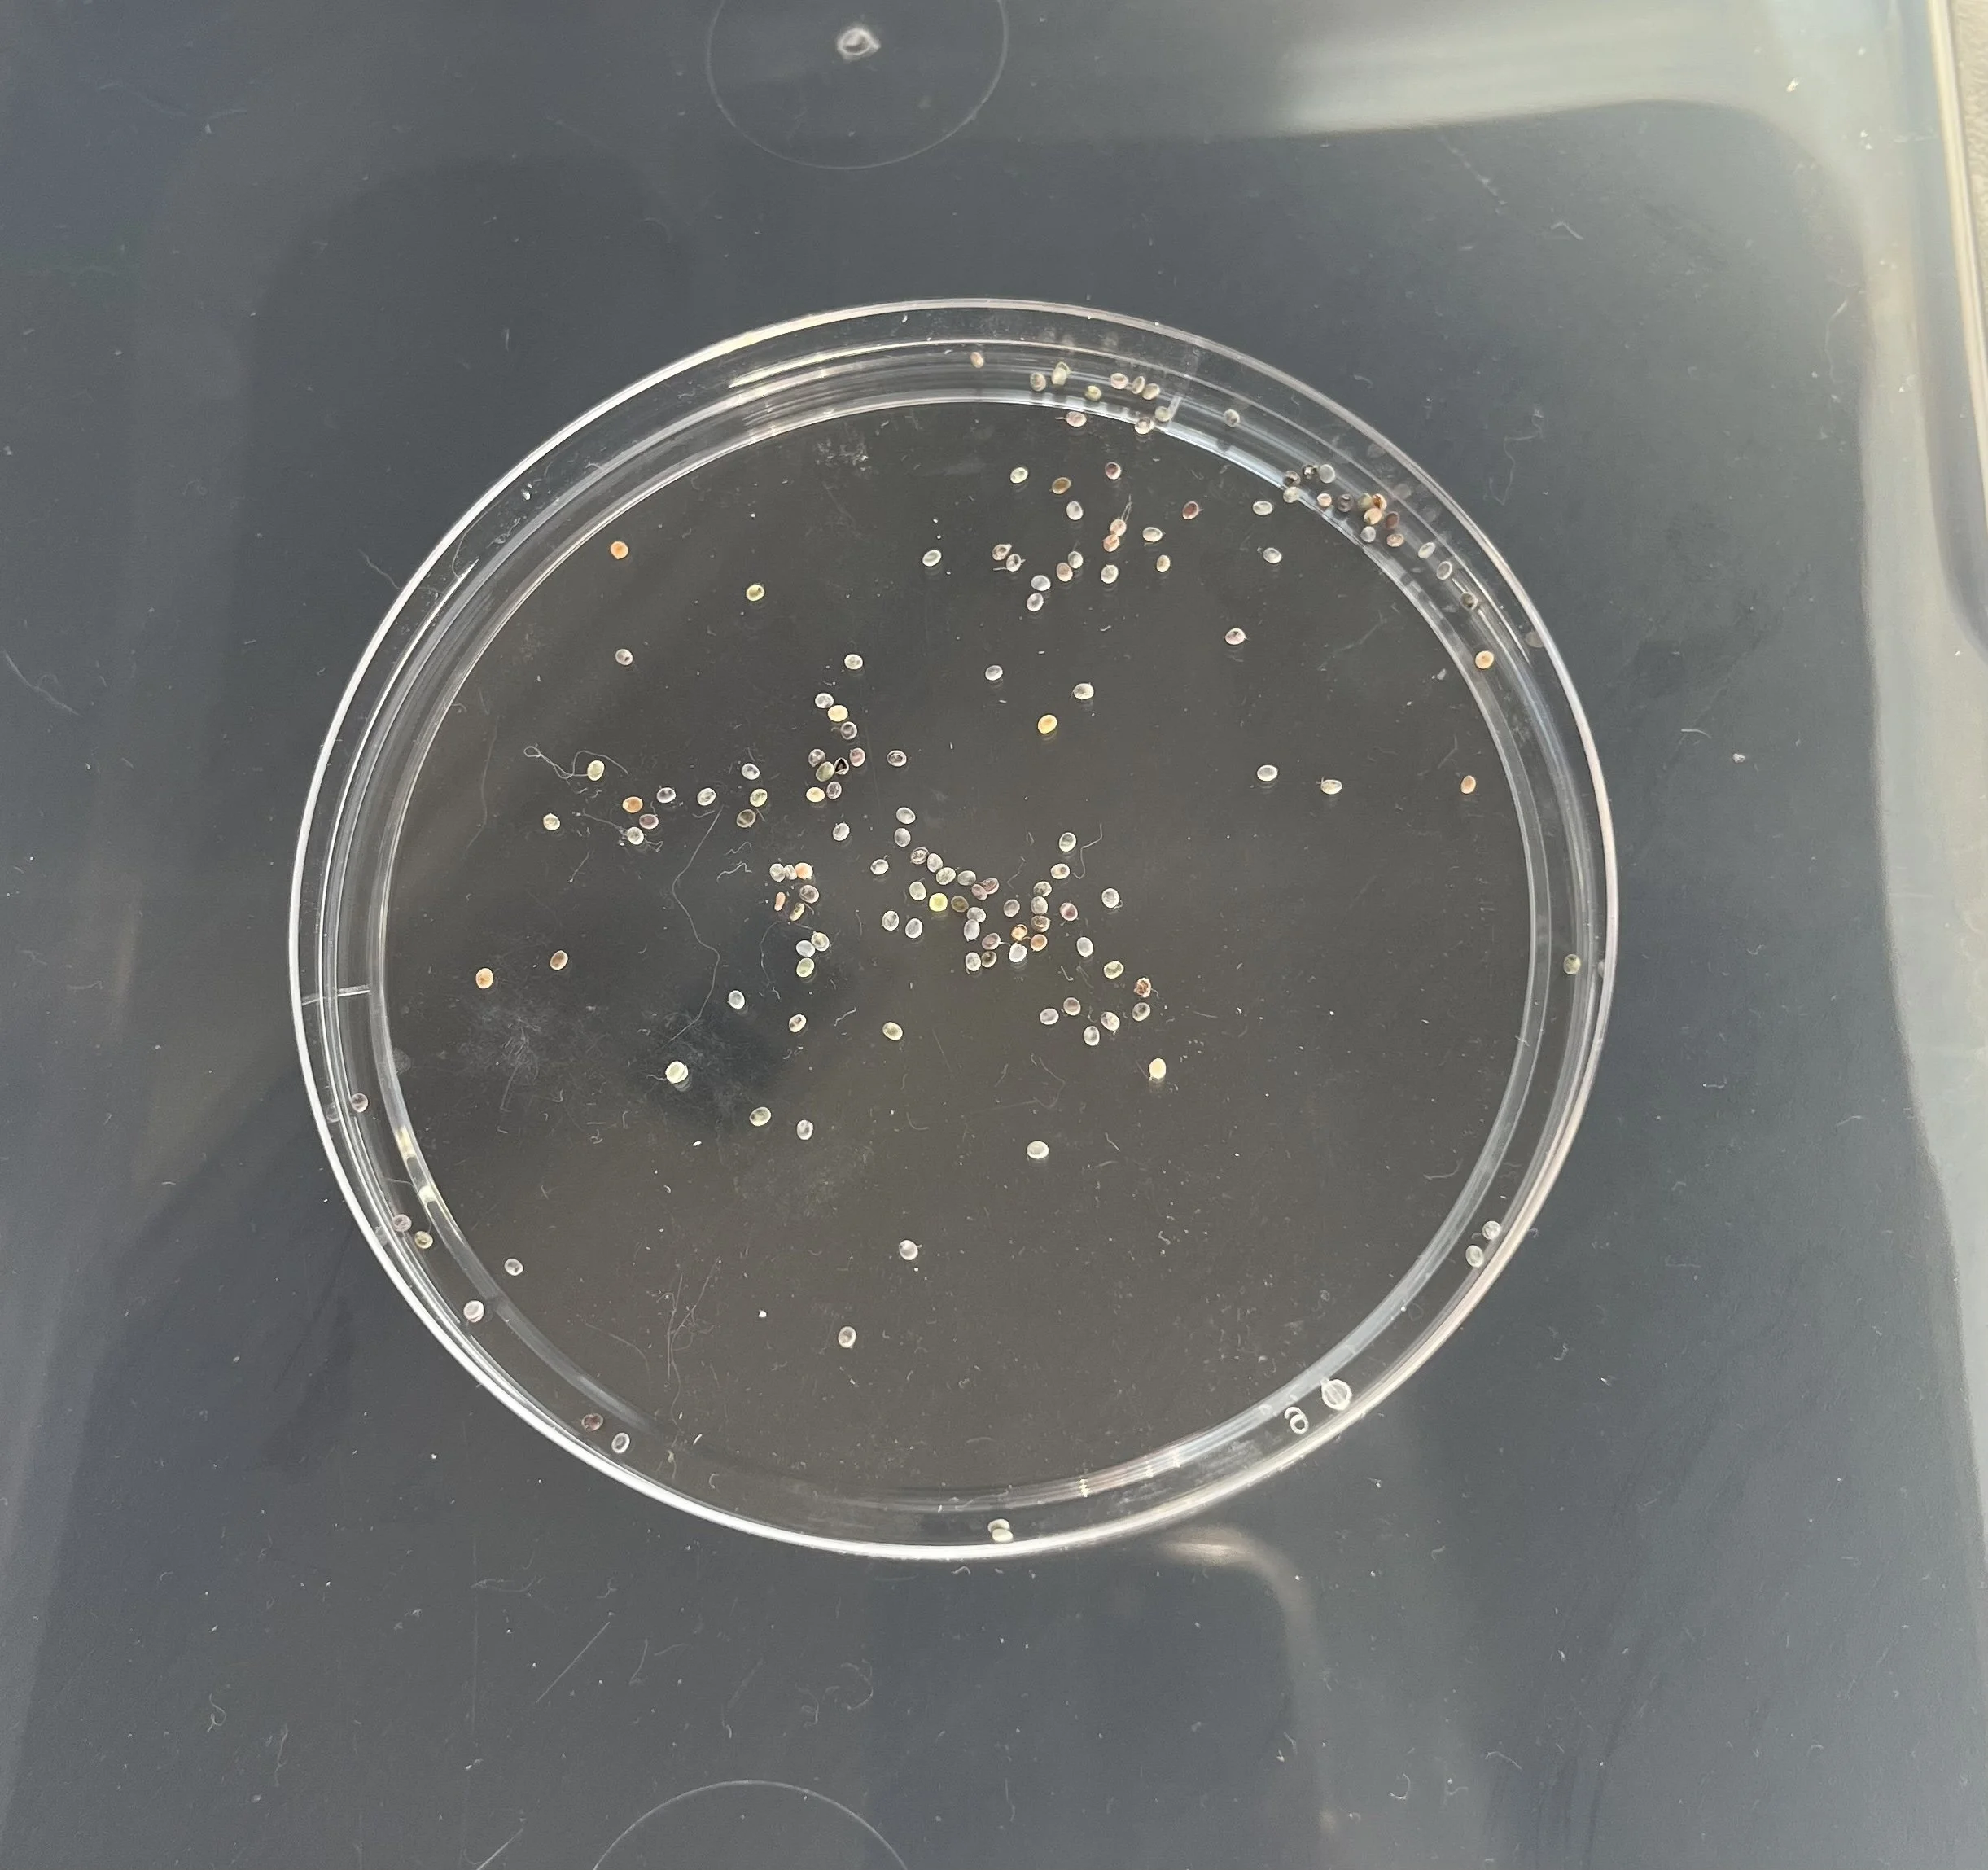
IMG_4855.jpg

Valentine Geze; sericulture study.
About.
The process of silk harvesting (sericulture) dates back as early as the Neolithic period in China (5000-3000 BCE) and grew in popularity among other Asian countries over the centuries. India and China hold the largest stake in silk production today, but other countries such as Japan, Korea, Russia, Italy, France, and Brazil also continue to practice sericulture. The process is done by raising silkworms, which are a species of caterpillar (Bombyx mori) whose cocoons are made entirely of fine silk fibers. When the cocoons are ready to be harvested, they are submerged in hot water to free the silk strands from the binding agent holding them together, in order to extract the individual silk fibers. Each cocoon is comprised of approximately 1,000 yards (910 meters) of silk. Individual fibers can then be combined to form thread via various weaving techniques that are regionally distinct.
As someone with a background in environmental engineering and a passion for creative weaving, I find the process of silk extraction fascinating. It is beautiful to think that every silk garment has come from this ancient practice spawned entirely from caterpillars. It is a process done by hand, free from any artificial fibers, and so harmonized with nature. The mere fact that these caterpillars turn into moths and leave behind this cocoon of strong and beautiful fiber is awe-inspiring. I place sustainability at the center of the pieces I create, so I decided to attempt this process myself as an opportunity to learn about natural fibers and take part in this tradition.
Silkworm Raising Process.
I ordered silkworm eggs online and received them in a petri dish. I placed the dish in a large plastic bin with a lid through which I punctured several air holes. I then affixed a heat lamp above the bin. After 10 days, the first worm emerged from an egg. The worm was tiny and black, and ready to begin eating. Silkworms only consume mulberry leaves, and since I was doing this project in February in Illinois, my best option was purchasing mulberry powder to create a paste. As more eggs began hatching, I kept the bin full with mulberry paste and watched as the worms grew rapidly. If the bin felt dry, I would place a very slightly damp paper towel inside to increase humidity while being wary of the threat of mold growth. Over a period of approximately 25-30 days, the worms grew from 3 millimeters to 3 inches in length.
They ate constantly throughout their lifetime and shed their skin four times throughout this process, as it does not stretch enough to accommodate the growth of the worm. Once the silkworms approached the end of their caterpillar lifecycle, I placed several cut-up rolls of paper towel inside the bin for the silkworms to begin cocooning. Once they were ready to cocoon, they began to release silk strands from their heads onto the walls of the paper towel rolls and spun themselves into perfect cocoons made entirely of silk. Within their cocoons, they began the process of becoming silk moths.
The silkworms remained in their cocoons for around three weeks, after which they pierced holes at the end of their cocoons and emerged as moths. The moth’s lifespan is only around 5 days, so they immediately began seeking mates to reproduce and lay eggs. The moths successfully reproduced and laid fertile eggs, which I placed in a container in the fridge to prevent them from hatching. I now have 60 cocoons that I can use to create garments to be worn and loved.